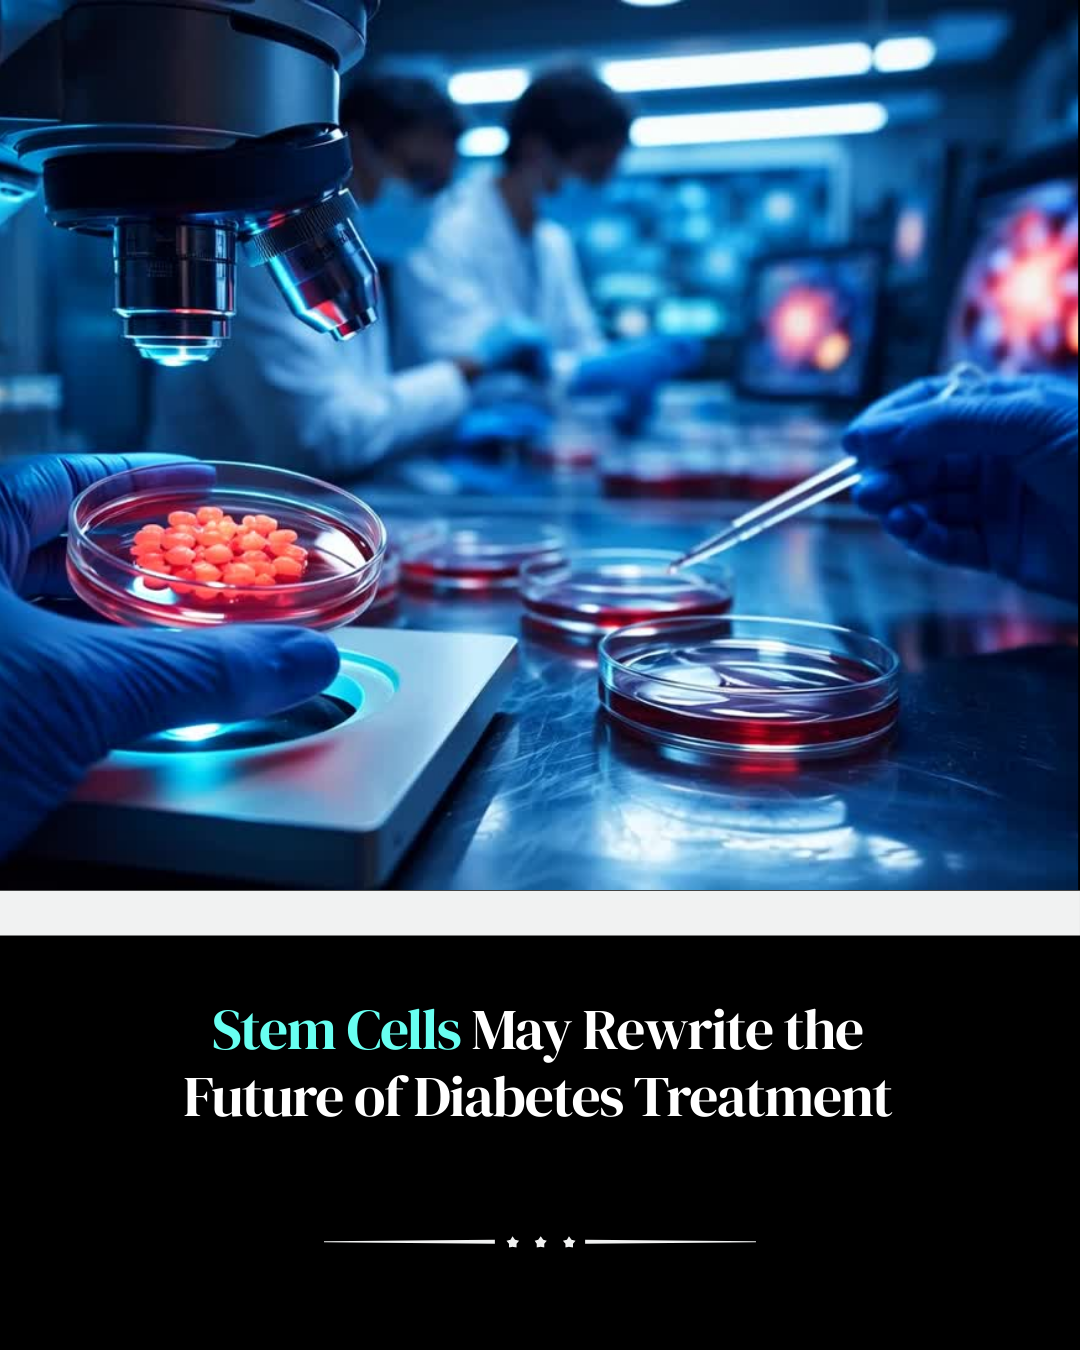
Stem cell therapy for diabetes treatment

Stem Cells May Rewrite the Future of Diabetes Treatment
Executive Summary
Diabetes management has historically centered on lifelong intervention, particularly through insulin administration. Emerging stem cell research suggests a potential shift in this paradigm. Early-stage trials indicate that transplanted insulin-producing cells may restore endogenous insulin production in some patients with both Type 1 and Type 2 diabetes. In certain cases, this has led to a reduction or temporary elimination of external insulin requirements. While these results remain preliminary and require long-term validation, the underlying concept represents a significant change: moving from symptom management toward biological restoration. The broader implication is not only clinical but systemic, as successful translation depends on coordination across research institutions, clinical systems, regulatory bodies, and industry stakeholders.
Introduction
Diabetes affects hundreds of millions of individuals globally and remains a major driver of long-term health complications. Current treatment strategies primarily focus on regulating blood glucose levels through medication, insulin therapy, and lifestyle management. These approaches are effective in controlling the condition but do not address the underlying loss or dysfunction of insulin-producing beta cells. Stem cell-based therapies aim to regenerate or replace these cells, enabling the body to produce insulin naturally. The approach involves differentiating stem cells into functional pancreatic cells and transplanting them into patients, where they integrate and begin producing insulin. This represents a shift from external regulation to internal restoration of metabolic function.
Market or Industry Context
The global burden of diabetes has created a substantial and growing market for treatment solutions. Pharmaceutical companies, research institutions, and biotechnology firms are actively exploring regenerative medicine as a pathway to long-term or curative therapies. Stem cell technology has advanced significantly in recent years, with improvements in cell differentiation, transplantation techniques, and immune compatibility. However, translating laboratory success into widely available treatment remains complex. Regulatory approval, manufacturing scalability, and cost considerations all influence adoption. Healthcare systems must also adapt to integrate advanced therapies that differ fundamentally from traditional pharmaceutical interventions.
Key Data Points and Observations
The reference highlights several important developments:
- Stem cell-derived insulin-producing cells have been successfully transplanted in early trials.
- Some patients have reduced or eliminated the need for external insulin.
- The approach applies to both Type 1 and Type 2 diabetes.
- The focus is shifting from management to biological restoration.
- Progress depends on coordinated efforts across research, clinical, and regulatory ecosystems.
These signals indicate that regenerative medicine may play an increasingly central role in future diabetes treatment strategies.
Implications for Healthcare Systems
If stem cell therapies prove safe and durable, healthcare delivery models may need to evolve significantly. Treatment could shift from continuous medication management to episodic interventions with long-term effects. This would impact not only clinical practice but also reimbursement structures, patient monitoring protocols, and healthcare infrastructure. Systems designed around chronic disease management would need to incorporate regenerative therapies that aim to restore function. Coordination between hospitals, specialized treatment centers, and long-term care providers would become essential to ensure effective patient outcomes.
Implications for Investors
For investors, regenerative medicine represents both opportunity and complexity. The potential market impact is substantial, given the global prevalence of diabetes. However, clinical risk remains high, particularly regarding long-term safety, immune response, and durability of transplanted cells. Investment decisions must consider the full development pathway, including clinical trials, regulatory approval, and manufacturing scalability. Companies that successfully navigate these stages may achieve significant value creation, but timelines are often extended. Strategic partnerships between biotech firms, healthcare providers, and regulatory bodies can accelerate progress and reduce uncertainty.
Risks, Limitations, or Open Questions
Several challenges remain before stem cell therapies can become standard treatment. Long-term safety and durability of transplanted cells must be established through extended clinical trials. Immune rejection and the need for immunosuppressive therapies present additional complications. Manufacturing consistency and cost-effectiveness are also critical factors for widespread adoption. Regulatory pathways for advanced therapies are complex and vary across regions. Furthermore, healthcare systems must be prepared to integrate these treatments at scale, which requires coordination across multiple stakeholders.
Outlook
The future of diabetes treatment may be shaped by the convergence of regenerative medicine, biotechnology, and healthcare system innovation. Stem cell therapies have the potential to redefine how chronic diseases are treated, shifting from management to restoration. However, scientific success alone is not sufficient. The translation of research into accessible treatment depends on alignment across research institutions, clinical systems, regulatory frameworks, and industry partners. If these elements converge effectively, the impact could extend beyond diabetes to other conditions where cellular function can be restored.
Frequently Asked Questions
Q1: How do stem cells help in diabetes treatment?
Stem cells can be differentiated into insulin-producing cells, which can then be transplanted into patients to restore natural insulin production.
Q2: Is this a cure for diabetes?
Current research is still in early stages. While promising, long-term safety and effectiveness must be validated before it can be considered a definitive cure.
Q3: What challenges remain for this technology?
Key challenges include immune rejection, long-term durability of transplanted cells, manufacturing scalability, and regulatory approval.
Summary
Stem cell research is opening the possibility of restoring the body’s ability to produce insulin, potentially transforming diabetes treatment from lifelong management to biological repair. Early trial results suggest meaningful progress, but widespread adoption will depend on scientific validation, regulatory approval, and coordinated healthcare implementation. The broader lesson is that major medical breakthroughs require not only scientific innovation but also alignment across the ecosystems that bring therapies to patients.